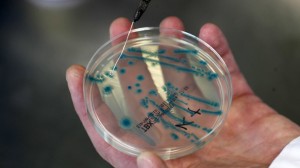

(Reuters) – The spread of deadly superbugs that evade even the most powerful antibiotics is no longer a prediction but is happening right now across the world, United Nations officials said on Wednesday.
Antibiotic resistance has the potential to affect anyone, of any age, in any country, the U.N.’s World Health Organisation (WHO) said in a report. It is now a major threat to public health and “the implications will be devastating”.
“We have a big problem now, and all of the trends indicate the problem is going to get bigger, said Keiji Fukuda, the WHO’s assistant director-general for health security.
In its first global report on antibiotic resistance, with data from 114 countries, the WHO said superbugs able to evade event the hardest-hitting antibiotics – a class of drugs called carbapenems – have now been found in all regions of the world.
“The world is headed for a post-antibiotic era, in which common infections and minor injuries which have been treatable for decades can once again kill,” Fukuda said. Drug resistance is driven by the misuse and overuse of antibiotics, which encourages bacteria to develop new ways of overcoming them.
For gonorrhoea, a dangerous sexually-transmitted disease that infects more than a million people across the world every day, antibiotic treatments are failing fast as superbug forms of the bacteria that causes it outpace them.
At least 10 countries – including Austria, Australia, Britain, Canada, France, Japan,Norway, South Africa, Slovenia and Sweden, now report having patients with gonorrhoea that is totally untreatable.
Only a handful of new antibiotics have been developed and brought to market in the past few decades, and it is a race against time to find more as bacterial infections increasingly evolve into “superbugs” resistant to even the most powerful last-resort medicines reserved for extreme cases.
One of the best known superbugs, MRSA, is alone estimated to kill around 19,000 people every year in the United States – far more than HIV and AIDS – and a similar number in Europe.
DRUGS DON’T WORK
The WHO said in some countries, because of resistance, carbapenems now do not work in more than half of people with common hospital-acquired infections caused by a bacteria called K. pneumoniae, such as pneumonia, blood infections, and infections in newborn babies and intensive-care patients.
Resistance to one of the most widely used antibiotics for urinary tract infections caused by E. coli – medicines called fluoroquinolones – is also very widespread, the WHO said.
In the 1980s, when these drugs were first introduced, resistance was virtually zero, according to the WHO report. But now there are countries in many parts of the world where the drugs are ineffective in more than half of patients.
“Unless we take significant actions to improve efforts to prevent infections and also change how we produce, prescribe and use antibiotics, the world will lose more and more of these global public health goods and the implications will be devastating,” Fukuda said in a statement.
Laura Piddock, director of the Antibiotic Action campaign group and a professor of microbiology at Britain’s Birmingham University, said the world needed to respond as it did to the AIDS crisis of the 1980s.
“Defeating drug resistance will require political will, commitment from all stakeholders and considerable investment in research, surveillance and stewardship programmes,” she said.
Jennifer Cohn of the international medical charity Médecins Sans Frontières agreed with the WHO’s assessment and confirmed the problem had spread to many corners of the world.
“We see horrendous rates of antibiotic resistance wherever we look in our field operations,” she said.





